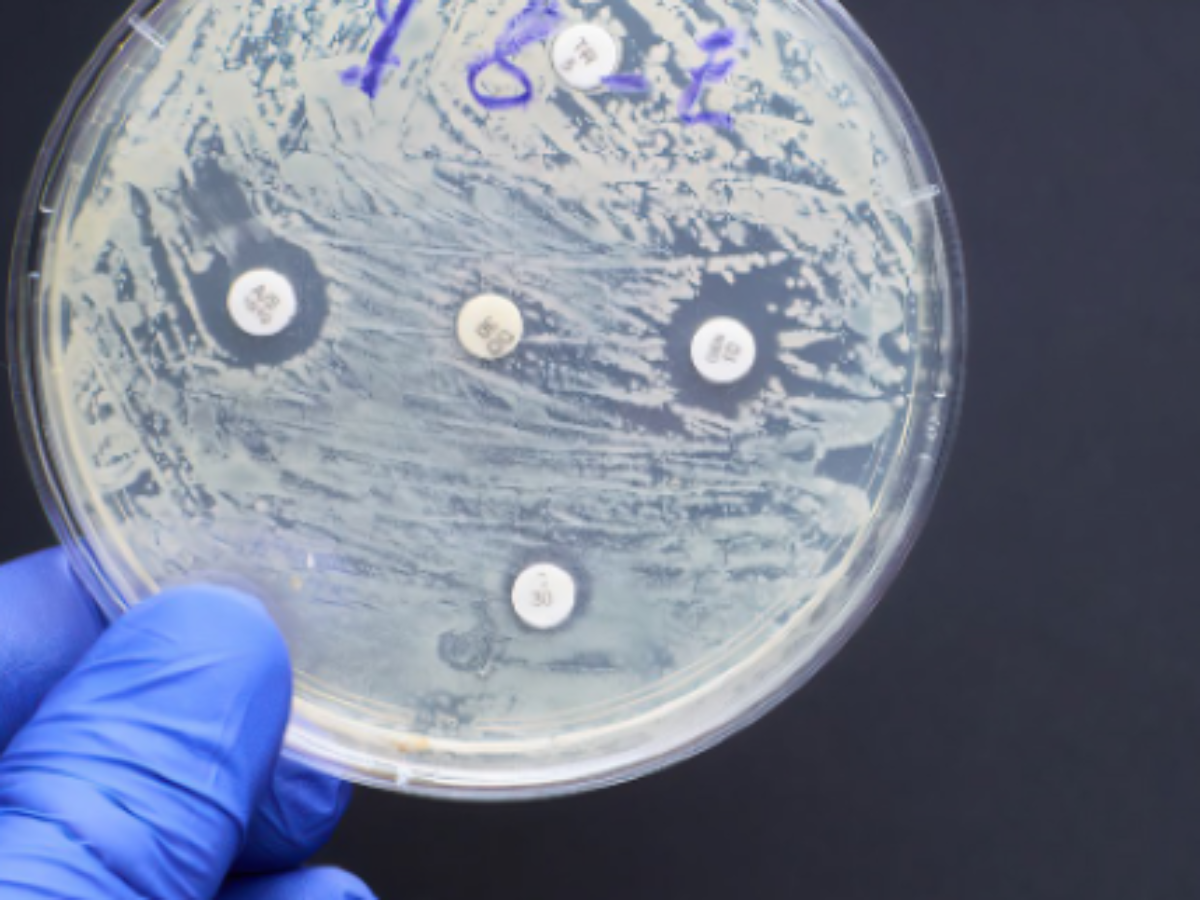

Boost commercialisation to beat microbes – report
Boosting pathways to commercialisation is seen as part of the answer to challenges Australia needs to overcome to avoid being thrust back into a pre-antimicrobial age where simple infections are deadly and some surgeries are too risky to perform.
Antimicrobial resistance (AMR) – when bacteria and other microbes become resistant to the drugs designed to kill them, such as antibiotics, usually from misuse or overuse – poses just such a challenge according to a new report.
The report, Curbing antimicrobial resistance: A technology-powered, human-driven approach to combating the ‘silent pandemic’, calls for greater national coordination and a focus on streamlining commercialisation processes for new antimicrobial resistance solutions and technologies.
It was developed by the Australian Academy of Technological Sciences and Engineering (ATSE) and initiated by science agency CSIRO.
ATSE CEO Kylie Walker said Australia has the potential to be a global contributor in the development of technologies to combat AMR and should aspire to be a world leader in its management.
Ms Walker said: “We have a wealth of creative AMR technology solutions emerging in Australia.
“We must support these innovations through the commercialisation process so they can be delivered in the settings they are needed, in a streamlined, sustainable, and coordinated way.”
The report supports work underway by the Minimising Antimicrobial Resistance Mission, developed by CSIRO with the Australian Departments of Agriculture, Fisheries and Forestry, and Health and Aged Care.
Dr Morgan said the report highlights the importance of a collaborative, preventative approach to AMR, which is a key tenet of the Mission.
“We aim to work with end-users, academic and industry partners to identify and prioritise solutions that have the greatest impact on preventing and managing further resistance,” Dr Morgan said.
Branwen Morgan, Lead of CSIRO’s Minimising Antimicrobial Resistance Mission, said AMR could render some of the most critical antimicrobial drugs ineffective, undermining modern medicine and making us vulnerable to drug-resistant infections .
“In Australia, modelling suggets AMR could potentially be responsible for over 5,000 deaths annually.”
The report looked at a range of potentially impactful technologies such as:
- Integrated surveillance and sensing solutions
- Point-of-care diagnostics
- Vaccination technologies
- Antimicrobial surfaces
- And air sterilisation technologies
Specific examples included surface sprays that change colour when pathogens are present, and toilets that detect and disarm harmful microbes before they reach our waterways.
Picture: CSIRO
@aumanufacturing Sections
Analysis and Commentary Awards casino reviews Defence Gambling Manufacturing News Online Casino Podcast Technology Videos

